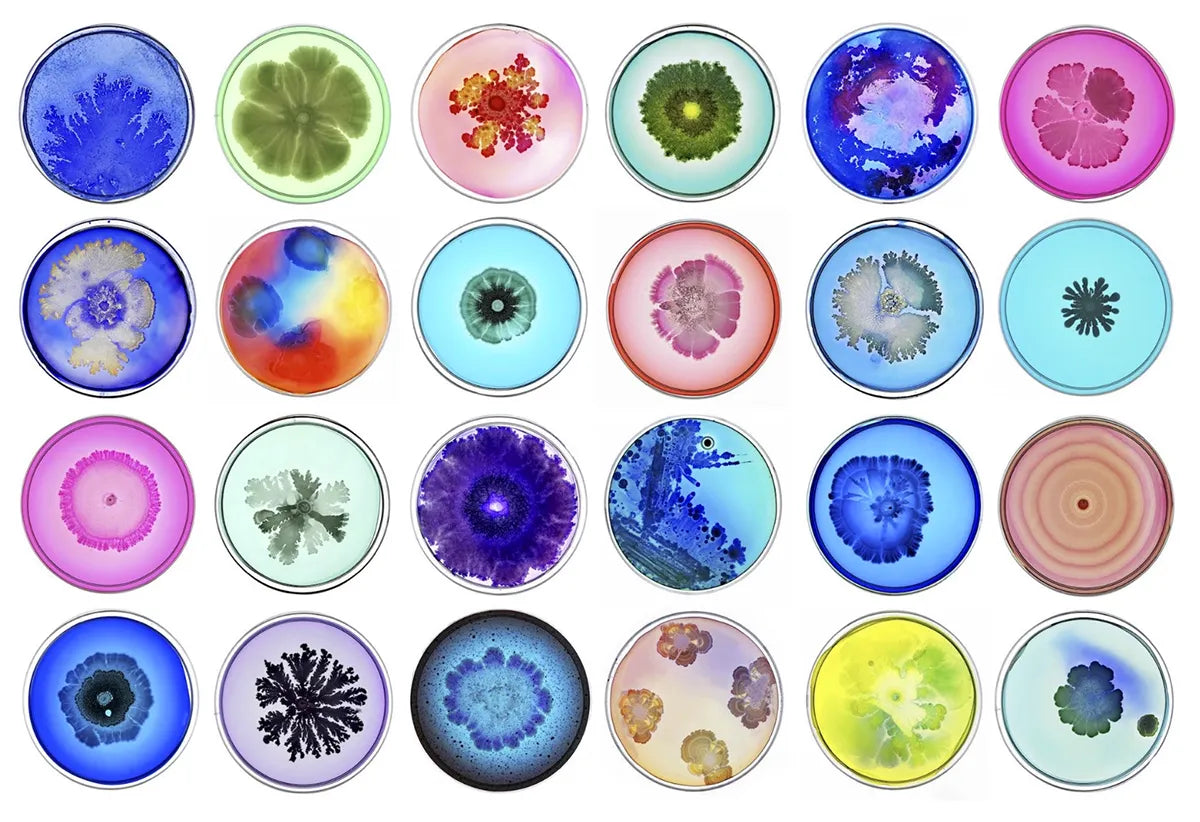

Our Science
Results from Clinical trials show
- All-natural Caffeine-free alternative without the “crash” phenomenon or jittery side effects you may experience from caffeine†
- Supports an increase in alertness and sustain alertness up to 5 h
- Provides sustained mental energy solution you can feel
- No interference to your sleep cycle
- Does not increase base heart rate

How does it work?
Made from a proprietary extract of Alpinia galanga, enXtra targets a cognitive process known as “Attention Network Function” (ANF), which is the ability of the brain to allocate processing resources to a specific task. The ANF system plays a critical role in mental alertness and the ability to focus on a task.
Mechanism of action: A molecular docking study of enXtra demonstrated that its phytoconstituents may interact with neurotransmitters such as dopamine and acetylcholinesterase that play a role in alertness and focus.
powerful medicinal herbs such as dandelion, chicory and carob have been used since ancient times

Dandelion Root
CLAIM / STUDY | RESOURCE |
---|---|
Improvement in liver function associated with restoring histopathology of the liver cells. | https://efsa.onlinelibrary.wiley.com/doi/10.2903/j.efsa.2009.1218 |
Dandelion prevents liver fibrosis, inflammatory response, and oxidative stress | https://link.springer.com/article/10.1186/s41936-020-00177-9 |
Dandelion helps normalise blood sugar levels. | https://pmc.ncbi.nlm.nih.gov/articles/PMC5553762/ |

Carob
CLAIM / STUDY | RESOURCE |
---|---|
Carob enhances gut health specifically on both pathogenic and probiotic bacteria. | https://akjournals.com/view/journals/066/52/4/article-p612.xml |
Carob contributes to improved metabolic health. | https://www.mdpi.com/2304-8158/11/14/2154 |
Carob has outstanding functional properties and nutritional profile and is rich source of a plethora of bioactive components. | https://www.tandfonline.com/doi/full/10.1080/10942912.2022.2164590?scroll=top&needAccess=true#references-Section |

Chicory
CLAIM / STUDY | RESOURCE |
---|---|
Chicory offers an anti-inflammatory, antimicrobial, antioxidant, hypolipidemic and hypoglycemic effect and also an important role in appetite regulation. | https://www.mdpi.com/2072-6643/14/5/957 |
Chicory affects bowel function, benefits butyrogenic trophic chains, and promotes glycaemic control. | https://www.cambridge.org/core/journals/gut-microbiome/article/dried-chicory-root-improves-bowel-function-benefits-intestinal-microbial-trophic-chains-and-increases-faecal-and-circulating-short-chain-fatty-acids-in-subjects-at-risk-for-type-2-diabetes/6209AEAFBDDB181197F22AE24388186B |
Chicory roots possess anti-inflammatory activity, inhibiting various cytokines, their antioxidant effects, and their free radical scavenging activity | https://journals.lww.com/asol/fulltext/2014/34010/Anti_inflammatory_activity_of_roots_of_Cichorium.8.aspx |
Chicory as a rich and versatile source of complex dietary fibers opens to combat a range of chronic metabolic diseases in fiber-poor diet. | https://pmc.ncbi.nlm.nih.gov/articles/PMC7360457/ |
Chicory: Understanding the Effects and Effectors of This Functional Food | https://www.mdpi.com/2072-6643/14/5/957 |
Role of short chain fatty acids in gut health and possible therapeutic approaches in inflammatory bowel diseases | https://www.wjgnet.com/2307-8960/full/v10/i28/9985.htm |

Alpinia Galanga
CLAIM / STUDY | RESOURCE |
---|---|
Enxtra (Alpinia Galanga) leads faster and more focused processing of information with an improvement inthe brain’s ability to concentrate for longer periods of time. | https://www.tandfonline.com/doi/epdf/10.2147/OAJCT.S164450?needAccess=true |
Alpinia Galanga improves alertness, accuracy, reaction time, and reduces errors in individuals. | https://www.proquest.com/openview/cb62df55474ba22ee85711e87e4bffc3/1?pq-origsite=gscholar&cbl=3933326 |
Alpinia Galanga has powerful cytotoxic, antibacterial, and antioxidant properties. | https://www.cell.com/heliyon/fulltext/S2405-8440(24)13227-6 |

B Vitamins Mix
CLAIM / STUDY | RESOURCE |
---|---|
B Vitamins contribute to cellular energy production translating into perceived relief from physical and mental fatigue as well as helping psychological and cognitive functions. | https://www.mdpi.com/2072-6643/12/1/228 |
Each sip supports these pillars of health:
-
🦠Gut Health:
Supporting your gut's complex ecosystem is crucial for everything from immunity to mood to hormonal balance. Chicory, Dandelion root and Carob, all rich in prebiotic fibres, feed the good bacteria in your gut, making your gut microbiome healthier, thus improving digestion, enhancing immunity, and reducing inflammation in your gut.
-
🧠 Brain-Boosting without the cortisol spikes, anxiety or jitters
EnXtra, our clinically researched nootropic from the ginger family, gives sustained focus and attention without the crash, jitters or sleep disturbances.
-
🧹 Daily detoxification support:
Did you know that your liver is one of the hardest-working organs in our body? A sluggish liver can lead to everything from energy to hormonal issues. Support your body in flushing toxins as a part of daily detox routines with Dandelion, a powerhouse detoxifier.

No crash
Our coffee alternative is a super blend of functional herbs such

Caffeine free
Our coffee alternative is a super blend of functional herbs such

Nutritious
Our coffee alternative is a super blend of functional herbs such

Good for gut
Our coffee alternative is a super blend of functional herbs such
OUR RANGE OF HERBAL BLENDS

